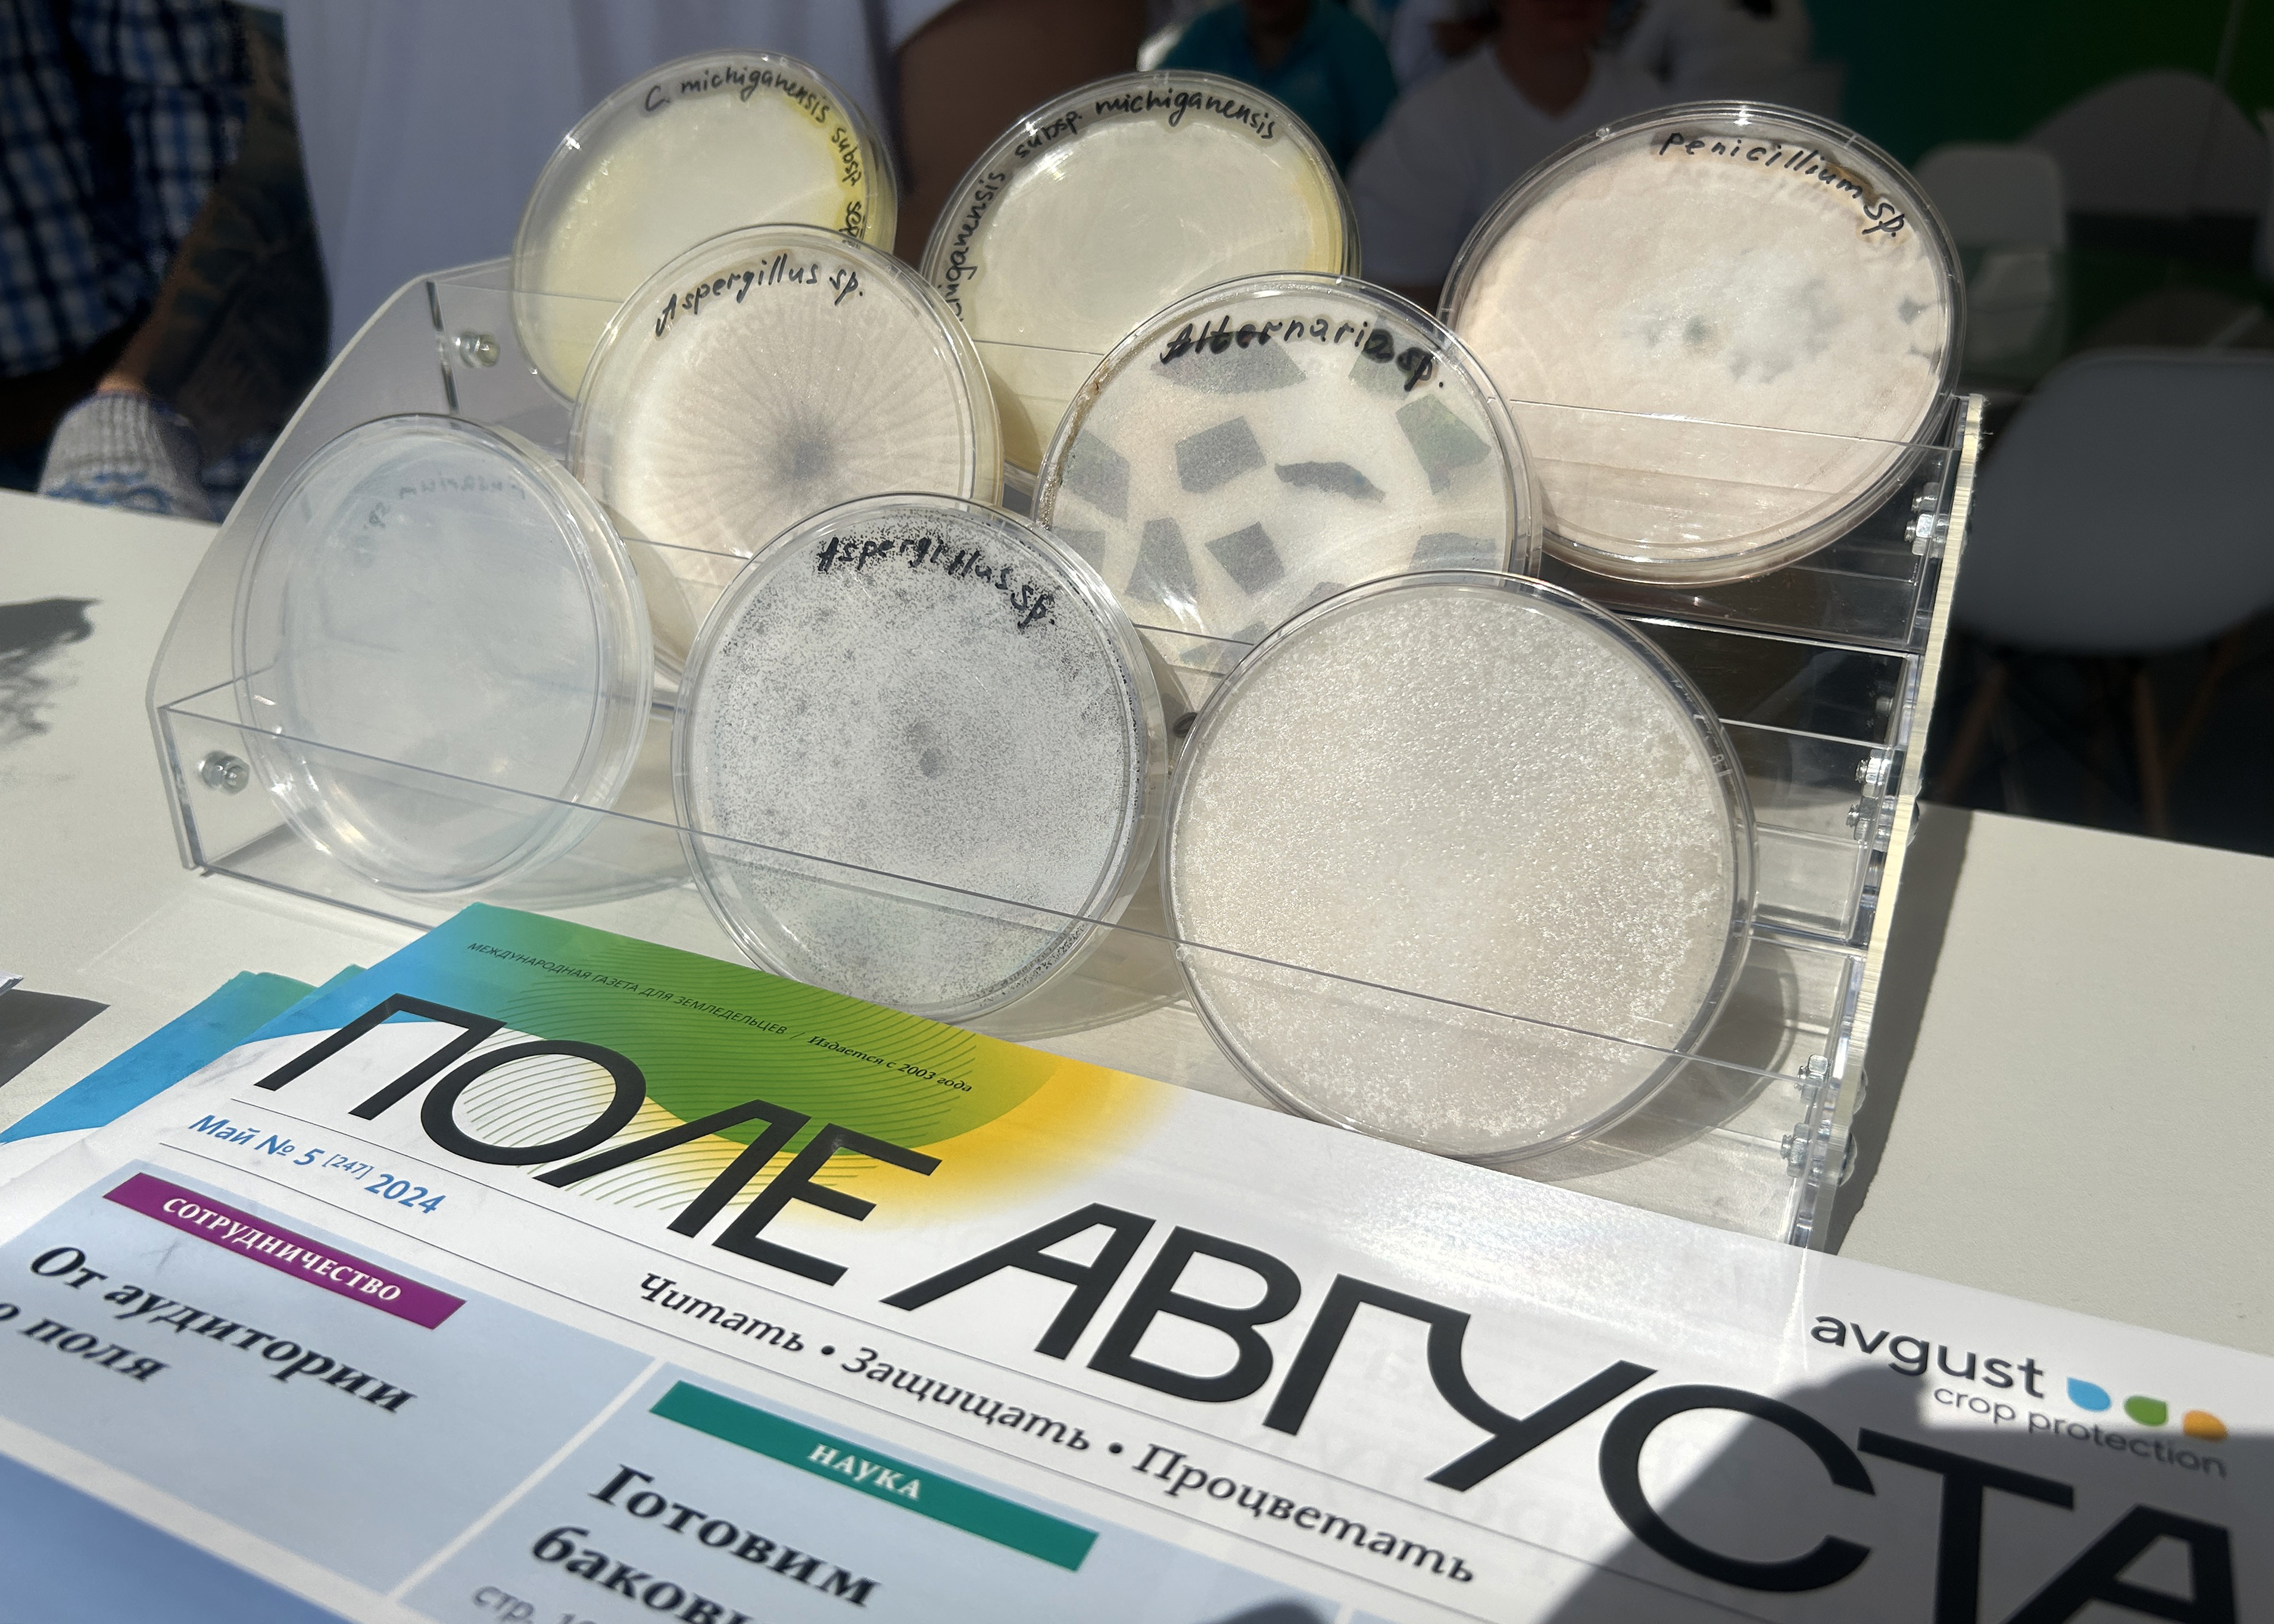
«День Донского поля» 2024

Нравится: 3
Сегодня в Ростовской области, в Аграрном научном центре «Донской» завершается выставка «День Донского поля».
На стенде «Августа» в течение двух дней работают сотрудники региональных представительств компании и специалисты лаборатории «Агроанализ-Дон».
Публикуем фоторепортаж с выставки.
До новых встреч на мероприятиях «Августа»!
На стенде «Августа» в течение двух дней работают сотрудники региональных представительств компании и специалисты лаборатории «Агроанализ-Дон».
Публикуем фоторепортаж с выставки.
До новых встреч на мероприятиях «Августа»!
14 июнь 2024

Авторизуйтесь, чтоб оставлять комментарии.